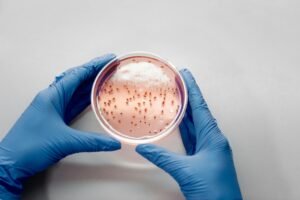
Close-up of gloved hands holding a petri dish with bacterial cultures for scientific analysis.

We are expert intellectual property litigators who deploy precision advocacy to maximize impact while meeting our clients’ strategic needs.
We offer a suite of legal services for your intellectual property needs.

We maximize results.
We believe IP litigation can be done differently—and better. Our team is driven to find the best and most efficient way to achieve our clients’ goals. We recognize that every case is different a requires a thoughtful approach to maximize your resources. We achieve results by finding and targeting the most important issues in your case.
Founded by award-winning intellectual property litigators who have represented companies big and small, we bring our unique perspective to help you navigate complex landscapes and protect your intellectual property. We are trusted by clients with their most important matters.
Read our insightful and timely commentary on IP and technology law.